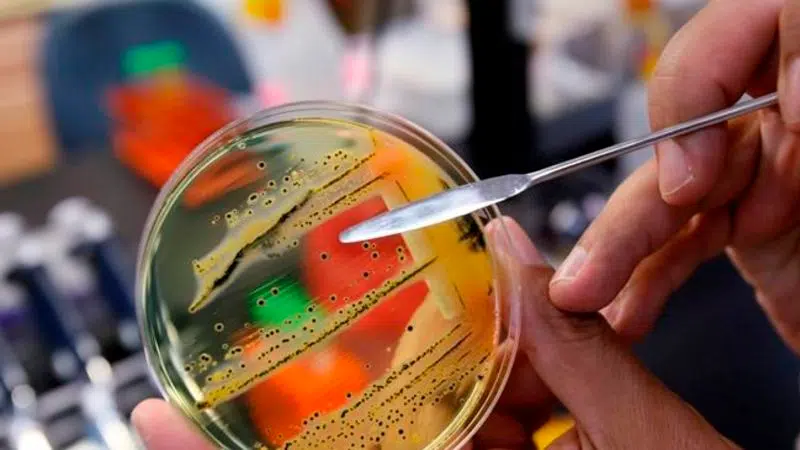

Author Archives:

With Brexit, Britain is in crisis and not for the first time
LONDON - Few would argue that Britain is in what is often referred to as a bit of a pickle. A crisis in fact, undoubtedly of historic proportions. With the country mired in confusion and recrimination...
Apr 05, 2019

Freeland says foreign election meddling in October federal vote is likely
OTTAWA - Foreign Affairs Minister Chrystia Freeland says it is likely that malign foreign actors will meddle in Canada's federal election in October. In fact, she says it is likely that efforts have a...
Apr 05, 2019
Two dead after salmonella outbreak at personal care home in Winnipeg
WINNIPEG - An official at a personal care home in Winnipeg says two people have died after testing positive for salmonella during an outbreak of the bacterial infection. Joyce Kristjans...
Apr 05, 2019

Trump drops border shutdown threat and proposes auto tariffs
WASHINGTON - Abandoning his threat to immediately seal the southern border, President Donald Trump warned instead that he'd slap tariffs on cars coming to the U.S. from Mexico unless the Mexicans do m...
Apr 05, 2019

Biden to make 1st appearance since complaints about behaviour
WASHINGTON - In countless conversations over the past year, former Vice-President Joe Biden, his advisers and his broad network of friends and family have openly discussed the vulnerabilities he would...
Apr 05, 2019

Man's claim gives false hope in yearslong missing boy case
CINCINNATI - A day of false hope has given way to questions about why a man would claim to be an Illinois boy who disappeared eight years ago. The FBI declared the man's story a hoax Thursday one day ...
Apr 05, 2019

Gone in 6 minutes: an Ethiopian Airlines jet's final journey
From nearly the moment they roared down the runway and took off in their new Boeing jetliner, the pilots of Ethiopian Airlines Flight 302 encountered problems with the plane. Almost immediately, a dev...
Apr 05, 2019

Attorney general defends handling of Mueller's Russia report
WASHINGTON - Attorney General William Barr is defending his handling of special counsel Robert Mueller's report on the Russia investigation, saying the confidential document contains sensitive grand j...
Apr 05, 2019

New Zealand mosque suspect to undergo mental health check
CHRISTCHURCH, New Zealand - A New Zealand judge on Friday ordered that the man accused of killing 50 people at two Christchurch mosques undergo two mental health assessments to determine if he's fit t...
Apr 05, 2019

Toronto Maple Leafs recall goalie Michael Hutchinson from AHL Marlies
TORONTO - The Toronto Maple Leafs recalled goalie Michael Hutchinson from the American Hockey League on Friday. The 29-year-old had a 2-3-0 record with a 2.64 goals-against average and a .914 save per...
Apr 05, 2019